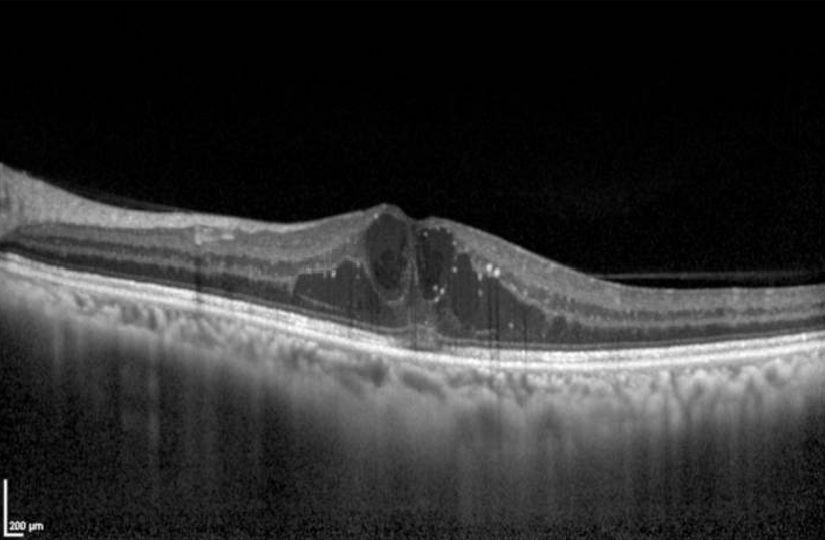

Vous recevez en consultation d’ophtalmologie un patient âgé de 65 ans, obèse (indice de masse corporelle [IMC] : 32 kg/m2) qui consulte pour un renouvellement de correction optique.
On note chez ce patient peu d’antécédents, hormis une dyslipidémie sous régime seul.
Votre examen révèle :
– une acuité visuelle à 5/10 aux deux yeux avec une correction de +1,00 -1 à 90° à droite et +1,75 -1,25 à 85° à gauche ;
– une tension oculaire mesurée au tonomètre de Goldmann à 16 mmHg ;
– une vision de près p4 aux deux yeux.
On note chez ce patient peu d’antécédents, hormis une dyslipidémie sous régime seul.
Votre examen révèle :
– une acuité visuelle à 5/10 aux deux yeux avec une correction de +1,00 -1 à 90° à droite et +1,75 -1,25 à 85° à gauche ;
– une tension oculaire mesurée au tonomètre de Goldmann à 16 mmHg ;
– une vision de près p4 aux deux yeux.
Question 1 - Cochez la ou les réponses exactes :
Le verre correcteur est convexe.
L’échelle Parinaud permet de définir l’acuité visuelle de près.
L’acuité visuelle de près normale est p2.